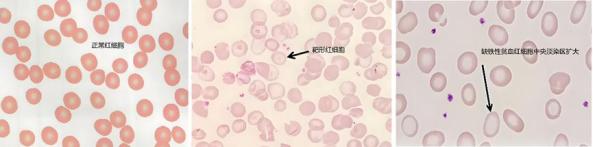

- +1
世界地中海贫血日——防控地贫,携手同行



 防控地贫
防控地贫携手同行
关爱生命,从了解地中海贫血开始
2025年5月8日是
第32个“世界地中海贫血日”,
今年的活动主题是
“防控地贫,携手同行”,
旨在提高社会公众特别是高发省份群众对地贫的认知和关注,
倡导全社会共同行动,
加强地贫筛查、早诊早治和健康管理工作。
 世界地贫日的由来
世界地贫日的由来世界地贫日是世界地中海贫血的简称,设在每年的5月8日,由国际地中海贫血联合会(简称国际地贫联盟)于1994年发起设立,旨在纪念已故的地中海贫血患者及其他血红蛋白病患者,同时提高公众对地贫的认知。
 什么是地中海贫血?
什么是地中海贫血?地中海贫血简称地贫,又称海洋性贫血,因最早发现与地中海沿海国家而得名。
地贫是一种由于血红蛋白的珠蛋白肽链基因突变或缺失,导致珠蛋白肽链合减少或缺失所引起的遗传性溶血性贫血。
地贫是全球分布最广、累及人群最多的一种单基因遗传病,主要见于地中海沿海国家和东南亚各国,我国长江以南的广西、广东、海南等省份为地贫高发区。
 地中海贫血的发病机制
地中海贫血的发病机制众所周知,人体血液中数量最多的细胞就是红细胞,红细胞中负责携带氧气的是血红蛋白,通过血液的流动把氧气输送到身体的各个角落,以供机体需要。血红蛋白由珠蛋白和血红素结合形成,珠蛋白包括2条类α珠蛋白肽链和2条类β珠蛋白肽链。编码α珠蛋白的基因定位于16号染色体,编码β珠蛋白的基因定位于11号染色体。
 根据累及的珠蛋白类型,常见的地贫主要分为两种,α地贫和β地贫。两种地贫为常染色体隐性遗传病,其发病与性别无关,男女患病几率相同,父母将异常基因传给子女。夫妇双方仅一方有地贫基因缺陷,或者一方为α地贫,另一方为β地贫,则不会孕育中重型地贫儿。但如果夫妇均是是带有同种基因缺陷的携带者(杂合子),则后代为地贫儿的概率为25%。
根据累及的珠蛋白类型,常见的地贫主要分为两种,α地贫和β地贫。两种地贫为常染色体隐性遗传病,其发病与性别无关,男女患病几率相同,父母将异常基因传给子女。夫妇双方仅一方有地贫基因缺陷,或者一方为α地贫,另一方为β地贫,则不会孕育中重型地贫儿。但如果夫妇均是是带有同种基因缺陷的携带者(杂合子),则后代为地贫儿的概率为25%。 地中海贫血的临床症状
地中海贫血的临床症状轻型患者
无明显症状或仅表现轻度贫血,偶尔头晕、容易疲劳,如静止型α地贫、标准型α地贫和轻型β地贫等。
中间型患者
可表现出明显的贫血症状,如面色苍白,头晕耳鸣,四肢酸软,有时可出现黄疸,部分患者甚至可出现肝脾肿大。
重型患者
重型β地贫(Cooley贫血)患者在出生后3个月—12个月开始发病,呈慢性进行性贫血,多表现为重度贫血,发育不良、黄疸、肝脾肿大等,其特殊面容为头颅变大、额部突起、两颊突出、鼻梁塌陷、眼距增宽等;
 重型α地贫(Hb Bart胎儿水肿综合征)大多数于妊娠30周—40周胎儿死于宫内或分娩后短期内死亡,伴有重度贫血、全身重度水肿和胸腹水。
重型α地贫(Hb Bart胎儿水肿综合征)大多数于妊娠30周—40周胎儿死于宫内或分娩后短期内死亡,伴有重度贫血、全身重度水肿和胸腹水。地中海贫血的实验室检查
血常规:贫血轻重不等,红细胞大小不一,表现为小细胞低色素性贫血(平均红细胞体积MCV、平均红细胞血红蛋白含量MCH、平均红细胞血红蛋白浓度MCHC低于正常参考值),需与缺铁性贫血相鉴别,地贫外周血可见靶形红细胞,血清铁蛋白正常或升高,而缺铁贫外周血红细胞中心淡染区扩大,血清铁蛋白降低。
地贫患者的初筛可通过血常规和血红蛋白电泳,针对高发地区出生的人群,若红细胞形态呈小细胞低色素改变,无论有无贫血,建议进一步进行地贫基因检测。
地贫患者的初筛可通过血常规和血红蛋白电泳,针对高发地区出生的人群,若红细胞形态呈小细胞低色素改变,无论有无贫血,建议进一步进行地贫基因检测。基因诊断是确诊地中海贫血携带者和患者最直接有效的检测方法!
地中海贫血的治疗
目前地贫患者尚无药物和成熟的基因治疗方法。
地贫基因携带者及轻型患者无需特殊治疗,中重型地贫患者需要定期输血和祛铁治疗维持生命,脾功能亢进者可行脾切除术,造血干细胞移植是目前可能治愈重型β地贫的方法。
 如何预防地中海贫血?
如何预防地中海贫血?地中海贫血难治可防
采用三级预防策略
目的是
降低重型地贫患儿的出生率
一级预防:婚前孕前预防
核心措施
通过基因检测阻断地贫遗传源头。
筛查流程
初筛:双方进行血常规、血红蛋白电泳检测。
确诊:初筛阳性者进一步接受地贫基因检测。
干预建议
若双方为同类型地贫基因携带者(α或β型),孕期需尽早产前诊断,或选择胚胎植入前遗传学诊断(PGD)技术实现优生。
免费人群
新婚及计划怀孕的深圳常住人口夫妇(具体以婚前及孕产优生健康检查要求为准)。
 二级预防:产前预防
二级预防:产前预防关键手段
孕期夫妻进行地贫产前筛查,发现同型地贫基因携带者需要进一步行产前诊断,避免重型地贫患儿出生。
诊断流程
孕早期通过绒毛穿刺、羊水穿刺或脐血穿刺,明确胎儿基因型。
干预建议
确诊为重型地贫胎儿(如Hb Bart's水肿胎、重型β地贫)建议医学干预终止妊娠。
免费人群
未接受过地贫筛查的建册怀孕夫妇。
 三级预防:地贫患儿早诊早治
三级预防:地贫患儿早诊早治关键手段
对贫血患儿进行地贫筛查,做到早发现、早治疗,预防和减轻疾病对患儿的影响。
筛查对象
所有新生儿(出生后足跟血筛查)。
健康体检中发现贫血的儿童。
干预方案
确诊患儿需定期输血、祛铁治疗;有条件者可评估造血干细胞移植可行性。
 地贫非高发区应该怎么做?
地贫非高发区应该怎么做?虽然不少地区不是地贫的高发区,但人员流动大,还是要慎重对待。
当发现血常规呈小细胞低色素性贫血的患者,要详细询问患者出生地、家族史、既往史、身体状况及营养状况等,必要时进行地贫基因的检测。
如果家族中有地中海贫血患者,应该及时进行下一步的检查,以免加重病情。由于地贫是遗传性的疾病,所以杂合子(携带者)筛查是实现人群监控目的的基本操作策略,在婚前和孕早期健康体检中进行此项遗传筛查是适宜的。
原标题:《世界地中海贫血日——防控地贫,携手同行》
本文为澎湃号作者或机构在澎湃新闻上传并发布,仅代表该作者或机构观点,不代表澎湃新闻的观点或立场,澎湃新闻仅提供信息发布平台。申请澎湃号请用电脑访问http://renzheng.thepaper.cn。





- 报料热线: 021-962866
- 报料邮箱: news@thepaper.cn
互联网新闻信息服务许可证:31120170006
增值电信业务经营许可证:沪B2-2017116
© 2014-2026 上海东方报业有限公司




